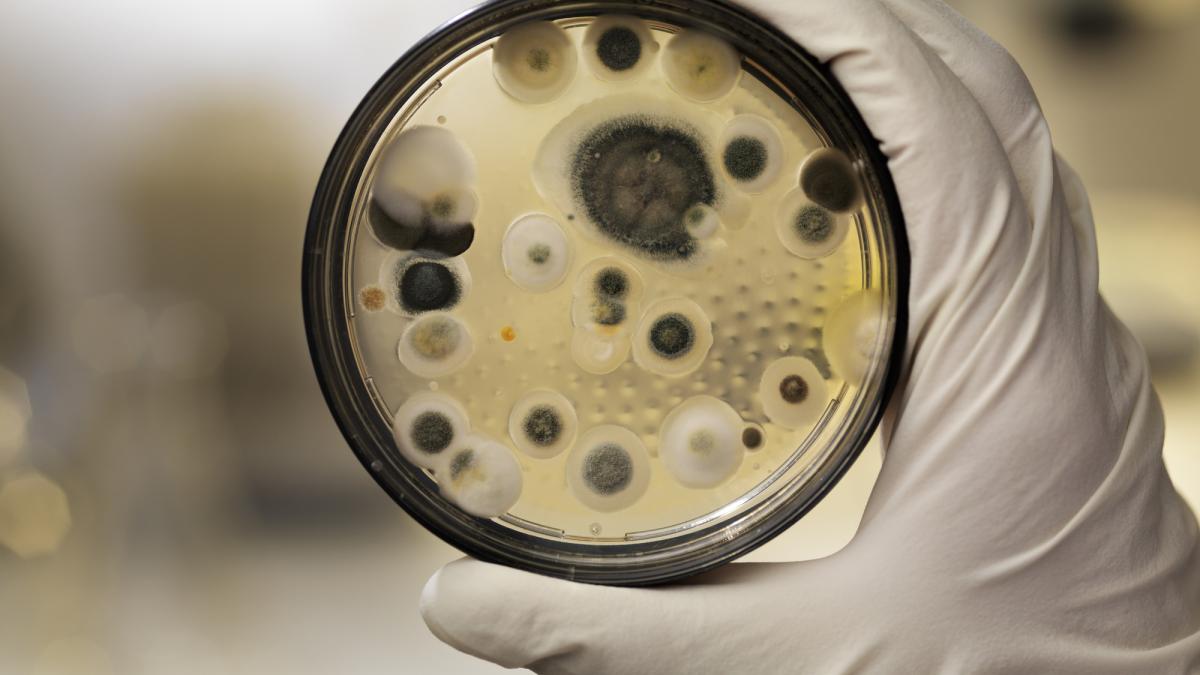
GettyImages-109727565.jpg

Cercetătorii au transformat o ciupercă asociată mult timp cu moartea într-o potențială armă împotriva cancerului
De la statutul de blestem al faraonilor, o ciupercă potențial letală, găsită în mormintele adăpostite de marile Piramide din Egipt deschise după milenii, a făcut un salt uriaș, care a propulsat-o în laboratoare de cercetare, unde a fost transformată în leac pentru cancer: Aspergillus flavus produce un nou medicament pentru combaterea leucemiei.
Într-o întorsătură remarcabilă a științei, cercetătorii au transformat o ciupercă asociată mult timp cu moartea într-o potențială armă împotriva cancerului. Găsită în morminte adăpostite de piramidele egiptene, precum cel al faraonului Tutankhamon (n. 1341 î.Hr. – d. 1323 î.Hr.), ciuperca Aspergillus flavus era odinioară de temut pentru sporii săi mortali. Acum, oamenii de știință de la Universitatea din Pennsylvania și instituțiile partenere au extras din această ciupercă o nouă clasă de molecule – numite asperigimicine – care dovedesc efecte puternice împotriva celulelor leucemice. Acești compuși, parte a unui grup rar cunoscut sub numele de RiPP fungice, au fost modificați genetic pentru potență și par să perturbe diviziunea celulelor canceroase cu specificitate ridicată.
Ciupercă mortală, medicament vital
Dar cum au transformat cercetătorii Universității din Pennsylvania o ciupercă mortală într-un compus puternic de combatere a cancerului? După ce au izolat o nouă clasă de molecule din Aspergillus flavus, ciuperca asociată cu decesele care au avut loc după o serie de săpături în siturile unor morminte antice egiptene, cercetătorii au modificat substanțele chimice și le-au testat împotriva celulelor leucemice. Rezultatul? Un compus promițător capabil să ucidă cancerul, care rivalizează cu medicamentele aprobate de Administraţia Americană pentru Alimente şi Medicamente (FDA) și deschide noi frontiere în descoperirea mai multor medicamente derivate din specii de fungi.
„Istoria ne amintește că ciupercile ne-au dat și penicilina”, spune Sherry Gao, profesor de inginerie chimică și biomoleculară și bioinginerie la Universitatea din Pennsylvania și autoare principală a noii lucrări despre Aspergillus flavus, publicate în Nature Chemical Biology. „Aceste rezultate arată că mai sunt încă de găsit multe alte medicamente derivate din produse naturale.”
De la blestem, la leac
După ce arheologii au deschis mormântul regelui Tutankhamon în anii 1920, o serie de decese premature în rândul echipei de excavare au alimentat zvonurile despre un blestem al faraonului. Decenii mai târziu, medicii au emis teoria că sporii fungici, latenți timp de milenii, ar fi putut avea un rol decisiv în decesele respective.
În anii 1970, 12 oameni de știință au intrat în mormântul lui Cazimir al IV-lea al Poloniei. În câteva săptămâni, 10 dintre ei au murit. Investigațiile ulterioare au dezvăluit că mormântul conținea Aspergillus flavus, ale cărei toxine pot duce la infecții pulmonare grave, în special la persoanele cu sistem imunitar compromis.
Acum, aceeași ciupercă este incredibila sursă a unei noi terapii promițătoare împotriva cancerului.
O descoperire rară
Terapia în cauză este o clasă de peptide sintetizate ribozomal și modificate post-translațional, sau RiPP. Numele se referă la modul în care este produs compusul de către ribozom, o structură celulară minusculă care produce proteine, și la faptul că este modificat ulterior, în acest caz, pentru a-i spori proprietățile de ucidere a cancerului.
„Purificarea acestor substanțe chimice este dificilă”, spune Qiuyue Nie, cercetător postdoctoral specializat în inginerie chimică și biomoleculară, coautor al lucrării. În timp ce mii de RiPP au fost identificate în bacterii, doar o câteva au fost găsite în ciuperci. În parte, acest lucru se datorează faptului că cercetătorii anteriori au identificat greșit RiPP-urile fungice ca peptide non-ribozomale și aveau cunoștințe insuficiente despre modul în care ciupercile au creat moleculele. „Sinteza acestor compuși este complicată, dar asta le conferă și o bioactivitate remarcabilă.”, adaugă Nie.
În căutarea substanțelor chimice
Pentru a găsi mai multe RiPP-uri fungice, cercetătorii au scanat mai întâi 12 tulpini de Aspergillus, despre care cercetările anterioare au sugerat că ar putea conține mai multe dintre aceste substanțe chimice.
Prin compararea substanțelor chimice produse de aceste tulpini cu elementele constitutive ale RiPP cunoscute, cercetătorii au identificat ciuperca Aspergillus flavus ca fiind un candidat promițător pentru studii suplimentare.
Analiza genetică a indicat o anumită proteină din Aspergillus flavus ca sursă de RiPP-uri fungice. Când oamenii de știință au dezactivat genele care creează acea proteină, markerii chimici care indicau prezența RiPP-urilor au dispărut și ei.
Această abordare nouă – combinând informații metabolice și genetice – nu numai că a identificat sursa RiPP-urilor fungice din Aspergillus flavus, dar ar putea fi utilizată pentru a găsi mai multe RiPP-uri fungice în viitor.
Un nou medicament puternic
După purificarea a patru RiPP-uri diferite, cercetătorii au descoperit că moleculele au o structură unică de inele interconectate și au numit aceste molecule, care nu au mai fost descrise anterior, după ciuperca în care au fost găsite: asperigimicine.
Chiar și fără modificări, atunci când au fost mixate cu celule canceroase umane, asperigimicinele au demonstrat potențial medical: două dintre cele patru variante au avut efecte puternice împotriva celulelor leucemice.
O altă variantă, la care cercetătorii au adăugat o lipidă, sau o moleculă grasă, care se găsește și în lăptișorul de matcă ce hrănește albinele în perioada de creștere și dezvoltare, a avut rezultate la fel de bune ca și citarabina și daunorubicina, două medicamente aprobate de FDA, utilizate de zeci de ani pentru tratarea leucemiei.
Codul de intrare în celulă
Pentru a înțelege de ce lipidele au sporit potența asperigimicinelor, cercetătorii au activat și dezactivat selectiv genele din celulele leucemice. O genă, SLC46A3, s-a dovedit a fi esențială în permiterea asperigimicinelor să pătrundă în celulele leucemice în număr suficient.
Această genă ajută materialele să iasă din lizozomi, micile săculețe care colectează material străin intrat în celulele umane. „Gena SLC46A3 acționează ca o poartă de acces”, spune Nie. – „Nu doar ajută asperigimicinele să pătrundă în celule, ci poate permite și altor «peptide ciclice» să facă același lucru.” La fel ca asperigimicinele, aceste substanțe chimice au proprietăți medicinale – aproape două duzini de peptide ciclice au primit aprobare clinică din anul 2000 și până în prezent, pentru a trata boli variate precum cancerul și lupusul – dar multe dintre ele necesită modificări pentru a pătrunde în celule în cantități suficiente.
„Faptul că știm acum că lipidele pot afecta modul în care această genă transportă substanțele chimice în celule ne oferă un alt instrument pentru dezvoltarea medicamentelor”, anticipează Nie.
Perturbarea diviziunii celulare
Prin experimente suplimentare, cercetătorii au descoperit că este posibil ca asperigimicinele să perturbe procesul de diviziune celulară. „Celulele canceroase se divid necontrolat”, spune Gao. – „Acești compuși blochează formarea microtubulilor, care sunt esențiali pentru diviziunea celulară.”
Compușii au avut un efect redus sau inexistent asupra celulelor canceroase de sân, ficat sau plămâni – sau asupra unei game de bacterii și ciuperci – sugerând că efectele perturbatoare ale asperigimicinelor sunt specifice anumitor tipuri de celule, o caracteristică critică pentru orice medicament viitor.
Direcții viitoare
Pe lângă demonstrarea potențialului medical al asperigimicinelor, cercetătorii au identificat grupuri similare de gene și în alte ciuperci, ceea ce sugerează că mai sunt de descoperit mai multe RiPPS fungice. „Chiar dacă au fost găsite doar câteva, aproape toate au o bioactivitate puternică”, spune Nie. „Aceasta este o regiune neexplorată, cu un potențial extraordinar.”
Următorul pas este testarea asperigimicinelor pe modele animale, cu speranța de a trece într-o zi la studii clinice pe oameni. „Natura ne-a oferit această farmacie incredibilă”, spune Gao. „Depinde de noi să-i descoperim secretele. Ca ingineri, suntem încântați să continuăm să explorăm, să învățăm de la natură și să folosim aceste cunoștințe pentru a proiecta soluții mai bune.”
PennU – cercetare la nivel academic
Studiul a fost realizat la Școala de Inginerie și Științe Aplicate a Universității din Pennsylvania, cunoscută sub numele mai popular de Penn University sau PennU, o instituție academică de cercetare din Ivy League – denumirea generică a unui grup de opt universități de cercetare private (din top 10) concentrate în nord-estul Statelor Unite, între care Harvard, Princeton sau Yale.
Penn University a fost înființată în 1755, în Philadelphia, prin eforturile fondatorului și primului președinte american Benjamin Franklin, care a pledat pentru o instituție de învățământ care să formeze viitori lideri ai mediului academic, economiei, comerțului și serviciilor publice. Printre absolvenții PennU se numără opt Părinți Fondatori ai Statelor Unite care au semnat Declarația de Independență, șapte care au semnat Constituția SUA, 24 de membri ai Congresului Continental, doi președinți ai Statelor Unite, 38 de laureați ai Premiului Nobel, nouă șefi de stat străini, trei judecători ai Curții Supreme a Statelor Unite, cel puțin patru judecători ai unor Curți Supreme ale altor națiuni, 32 de senatori americani, 163 de membri ai Camerei Reprezentanților SUA, 19 miniștri, 46 de guvernatori, 36 de miliardari în viață (cel mai mare număr dintre toate colegiile sau universitățile din SUA) și cinci laureați ai Medaliei de Onoare.
Astăzi, la PennU, campusurile și alte proprietăți acoperă câteva sute de hectare, activele fixe se apropie de valoarea de 50 de miliarde de dolari, iar sumele investite în cercetare (fonduri proprii, donații sau fonduri guvernamentale) se situează anual în jurul sumei de 5 miliarde de dolari.























